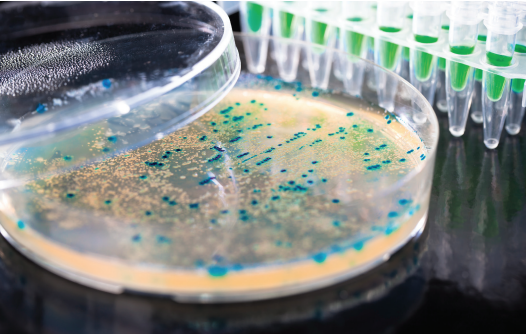

Posts
Showing posts from December, 2020
Anti-ageing; To stay away from diseases
- Get link
- X
- Other Apps
war in the micro world (Bacteriophages Vs Superbugs)
- Get link
- X
- Other Apps
Side effects of COVID-19 vaccine happening currently
- Get link
- X
- Other Apps